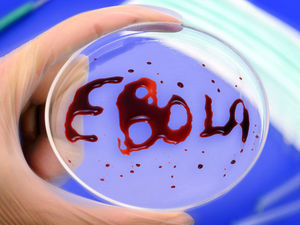

Хятадын тэрбумтнуудыг Жек Ма тэргүүлжээ
- 2017 оны 05 сарын 18


http://www.ugluu.mn/275106.html



http://www.zuv.mn/page/newsmore/11440

http://www.shuud.mn/content/read/483320.htm


http://www.zuv.mn/page/newsmore/11408

http://www.zaluu.com/read/12a8gd78c

http://www.zuv.mn/page/newsmore/11391

http://www.shuud.mn/content/read/483259.htm

http://www.shuud.mn/content/read/483183.htm

http://www.zuv.mn/page/newsmore/11302

http://www.zuv.mn/page/newsmore/11258


http://www.ugluu.mn/273817.html

http://www.shuud.mn/content/read/483036.htm

http://www.shuud.mn/content/read/483006.htm